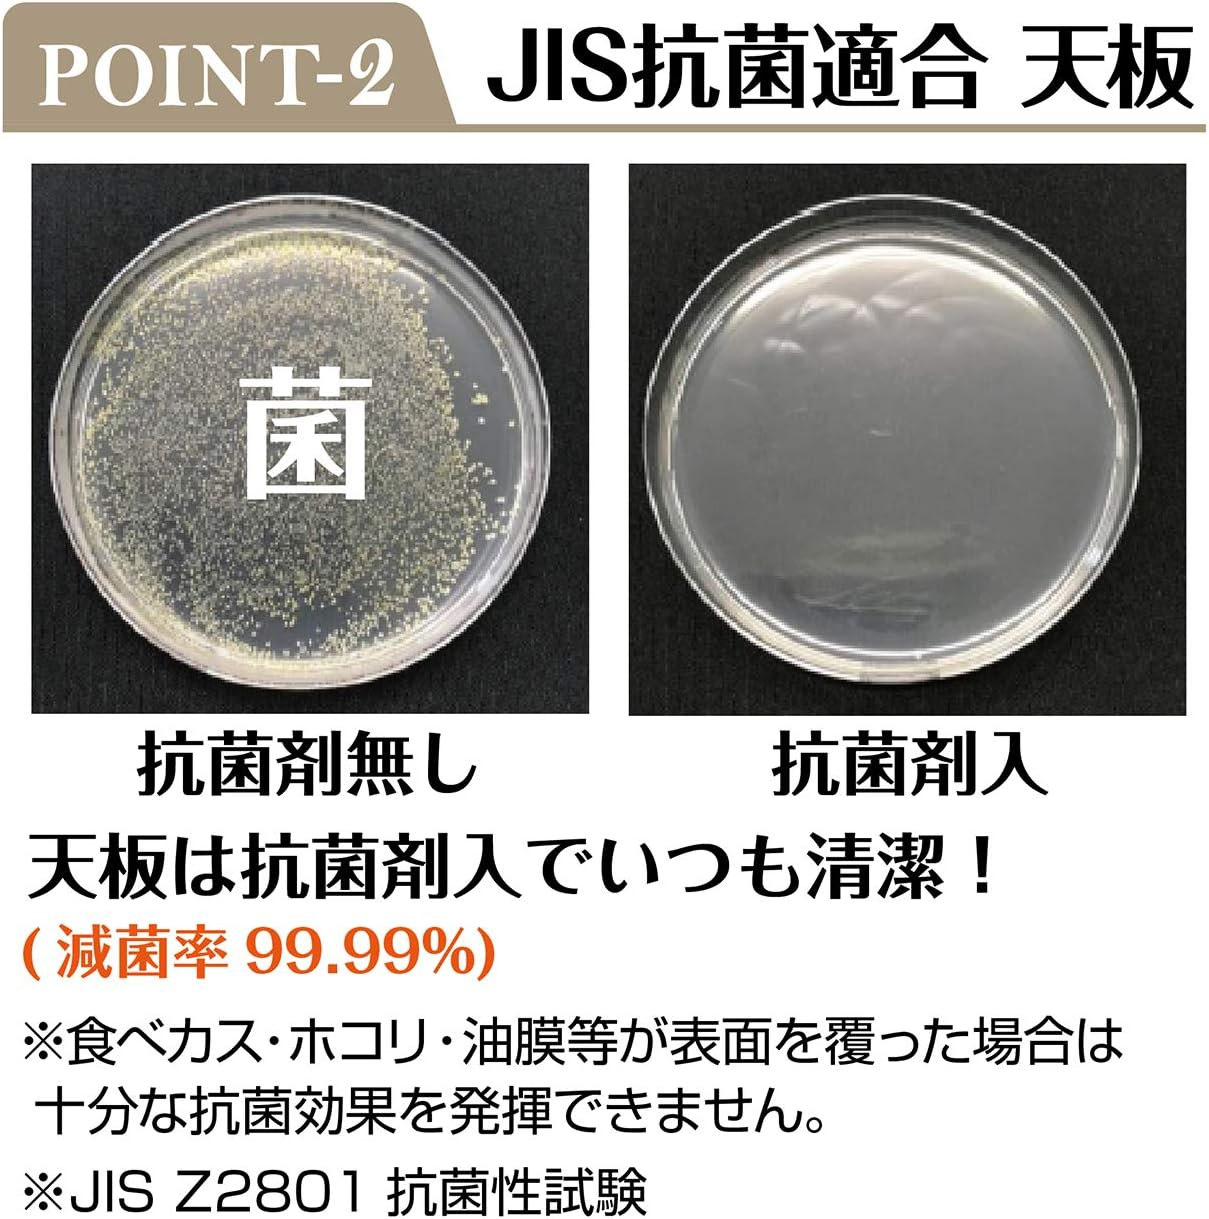
Petio Add Mate Villa Fort Adjustable Cat Dining Table image number 6

Free Shipping – Store Wide
Petio Add Mate Villa Fort Adjustable Cat Dining Table


Petio Add Mate Villa Fort Adjustable Cat Dining Table
Brand: ADD.MATE
A$139.80
Availability:
-
This item is currently not available
Shop with confidence
- Item Package Dimension: 14.0551180959L x 7.480314953W x 2.5984251942H inches
- Item Package Weight - 2.0502990366 Pounds
- Item Package Quantity - 1
- Product Type - PET FEEDER
Petio Add Mate Villa Fort Adjustable Cat Dining Table features with 3 level adjustable angle and height to suit your cat sizes and needs. Raising the feeding bowl makes it easier to eat and swallow. Also reduces back and neck pressure during eating.
- Capacity: 369 Grams
- Product dimensions: 18 x 35 x 6 cm; 870 Grams
- Material: ABS, PVC
- Model Number: A26135
- Item Weight: 870 g
- Special Features: Antibacterial
- Brand: ADD.MATE
- Style Name: Cat Table
- Colour: Black
A$139.80
Shipping to Australia
Delivery time varies by location
Return & Refund Policy
Check our return & refund policy
Security & Privacy
Safe payments: We do not share your personal
details
Availability:
-
This item is currently not available
Sign
in
or create an eMega account
Shop smarter — get exclusive deals & order
tracking